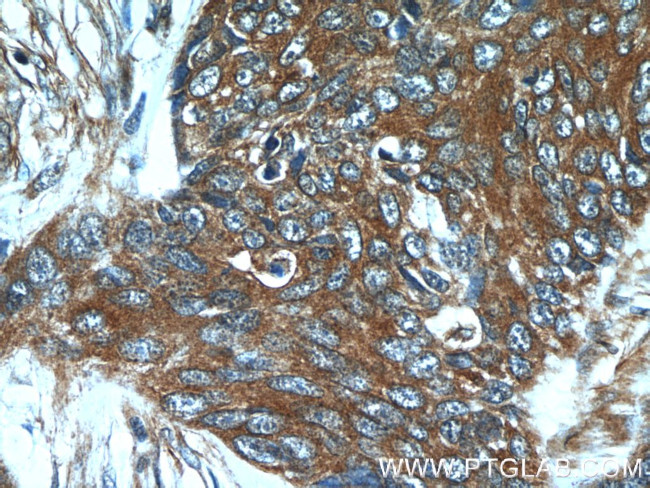
GJB6 Antibody in Immunohistochemistry (Paraffin) (IHC (P))

Search
Proteintech
GJB6 Polyclonal Antibody
{{$productOrderCtrl.translations['antibody.pdp.commerceCard.promotion.promotions']}}
{{$productOrderCtrl.translations['antibody.pdp.commerceCard.promotion.viewpromo']}}
{{$productOrderCtrl.translations['antibody.pdp.commerceCard.promotion.promocode']}}: {{promo.promoCode}} {{promo.promoTitle}} {{promo.promoDescription}}. {{$productOrderCtrl.translations['antibody.pdp.commerceCard.promotion.learnmore']}}
产品信息
24215-1-AP
种属反应
宿主/亚型
分类
类型
抗原
偶联物
形式
浓度
规格
纯化类型
保存液
内含物
保存条件
运输条件
产品详细信息
Immunogen sequence: ISRPTEKTV FTIFMISASV ICMLLNVAEL CYLLLKVCFR RSKRAQTQKN HPNHALKESK QNEMNELISD SGQNAITGFP S (182-261 aa encoded by BC038934)
靶标信息
Gap junctions allow the transport of ions and metabolites between the cytoplasm of adjacent cells. They are formed by two hemichannels, made up of six connexin proteins assembled in groups. Each connexin protein has four transmembrane segments, two extracellular loops, a cytoplasmic loop formed between the two inner transmembrane segments, and the N- and C-terminus both being in the cytoplasm. The specificity of the gap junction is determined by which connexin proteins comprise the hemichannel. In the past, connexin protein names were based on their molecular weight, however the new nomenclature uses sequential numbers based on which form of the gap junction is present. This gene encodes one of the connexin proteins. Mutations in this gene have been found in some forms of deafness and in some families with hidrotic ectodermal dysplasia.
仅用于科研。不用于诊断过程。未经明确授权不得转售。
篇参考文献 (0)
生物信息学
蛋白别名: connexin 30; Connexin-30; Cx30; ectodermal dysplasia 2, hidrotic (Clouston syndrome); Gap junction beta-6 protein; gap junction protein beta 6; gap junction protein, beta 6, 30kDa; unnamed protein product
基因别名: CX30; DFNA3; DFNA3B; DFNB1B; ECTD2; ED2; EDH; GJB6; HED; HED2
UniProt ID: (Human) O95452
Entrez Gene ID: (Human) 10804